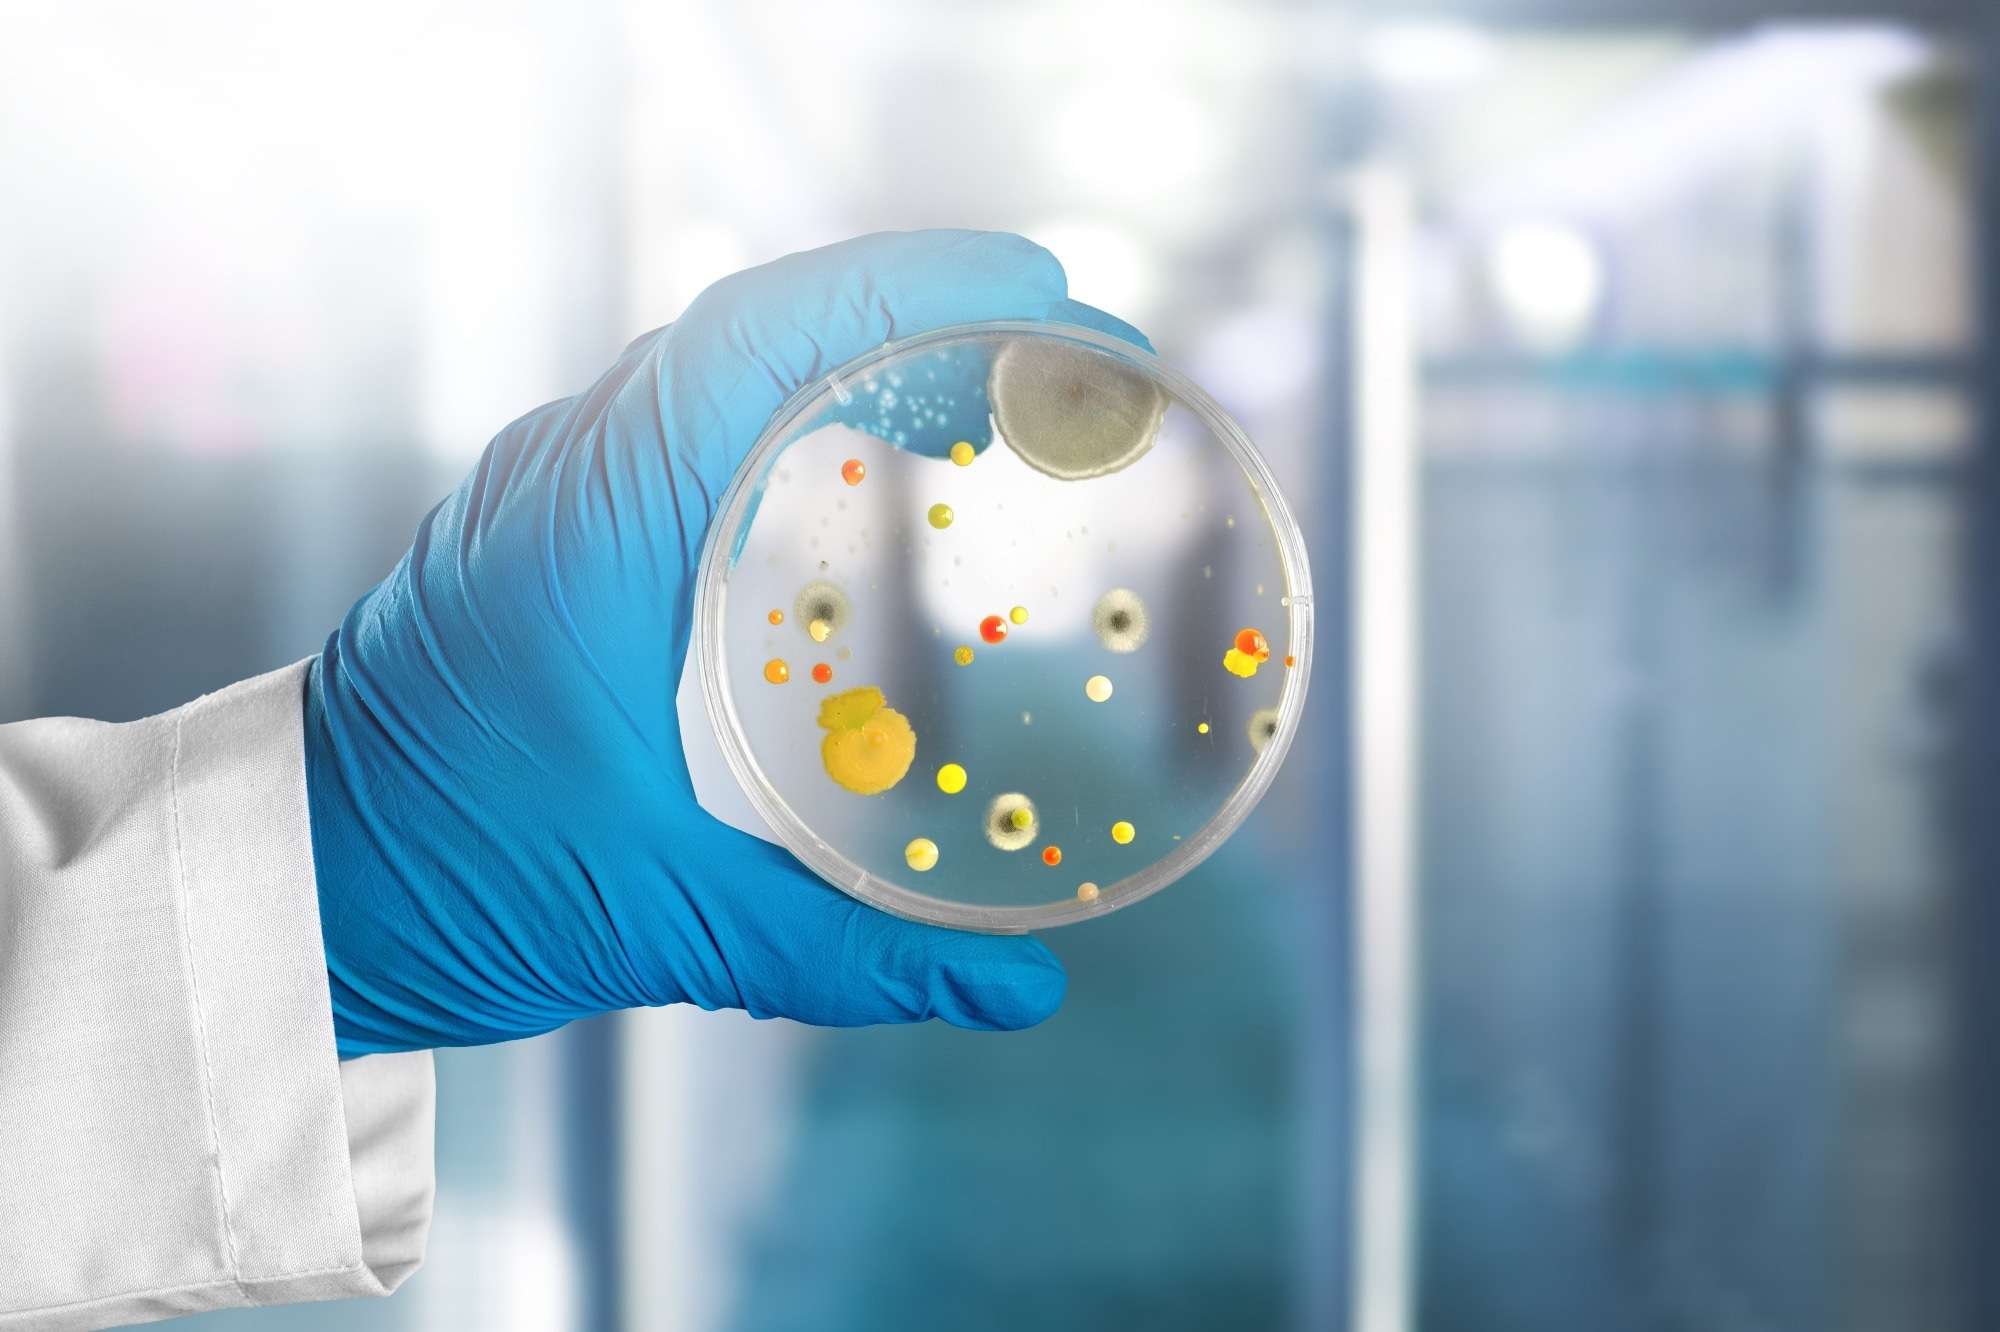

Introduction
How urban environments shape microbial communities
Biological mechanisms linking urban microbes to human health
Outdoor vs. indoor urban microbial exposure
Urban design and microbial health opportunities
Future directions and knowledge gaps
References
Further reading
From green spaces to indoor air and plumbing systems, the urban microbiome may help explain how city design influences immune health, respiratory risk, and the future of healthier buildings.
 Image Credit: Yana Tsap / Shutterstock.com
Image Credit: Yana Tsap / Shutterstock.com
Introduction
Cities are home to complex microbial ecosystems collectively known as the urban microbiome. This microbial community consists of diverse bacteria, viruses, fungi, and other microorganisms that proliferate throughout soil, water, and air, as well as on building surfaces and in public transport systems.1 These microbiomes also include non-living microbial components such as metabolites, proteins, and genetic material, which may influence human health even in the absence of viable organisms.4
How urban environments shape microbial communities
The impact of built structures and indoor spaces on urban microbiome composition is determined by architectural layout, ventilation systems, the choice of building materials, and other factors such as temperature and humidity.1 Additional determinants include human occupancy patterns, cleaning practices, and interactions between indoor and outdoor environments.1,3,4 Natural ventilation and daylight can introduce outdoor microorganisms into the indoor environment and may increase community richness, which contrasts with sealed and mechanically ventilated spaces that often contain less diverse communities.
As city residents occupy homes and workplaces, they introduce microorganisms into indoor environments, shaping the built microbiome. Supporting this, increased levels of Klebsiella and Escherichia have been detected indoors, particularly after building occupancy, reflecting a shift from outdoor-derived to human-associated microbial communities.3
Surface composition also modulates microbial dynamics: porous materials can retain microorganisms and facilitate biofilm formation, whereas high-touch areas promote microbial exchange. HVAC systems, plumbing, and water systems can also act as reservoirs that influence microbial persistence and transport.4 In crowded or poorly ventilated spaces, these conditions allow aerosols to persist for extended durations, which increases the risk of respiratory pathogen transmission.1-3
Microbial reservoirs in soil and other green spaces also contribute to urban microbial diversity. Specifically, these organisms are transported into the air and indoor environments through the circulation of dust and air, with plant-rich areas often supporting more diverse airborne microbial communities.2
The concentration of microorganisms in the environment varies with land use, pollution, and climate. Bodies of water, sewage systems, and other areas with stagnant water can affect microbial diversity and serve as important reservoirs for microbial transmission. These reservoirs, along with dust, pets, and human shedding, create interconnected microbial exchange networks between outdoor and indoor environments.4
Image Credit: Billion Photos / Shutterstock.com
Image Credit: Billion Photos / Shutterstock.com
Biological mechanisms linking urban microbes to human health
Microorganisms within the urban microbiome can be beneficial or harmful to human health, depending on exposure patterns. For example, early-life exposure to environmental microbes can train the immune system by increasing tolerance and reducing the risk of allergies, inflammatory diseases, and asthma.2 This concept aligns with the “biodiversity” and “old friends” hypotheses, which propose that reduced exposure to diverse environmental microbiota may contribute to immune dysregulation.2
Children exposed to microbially rich environments, such as homes with pets or access to natural settings, often have lower rates of atopy. Compared with children residing in less sanitized settings with more diverse microbes, those in highly sanitized settings may have poorer immunity and, as a result, be more susceptible to allergic and autoimmune conditions. Importantly, these responses vary with the extent and duration of exposure and individual susceptibility.2,4
Urban microorganisms in damp or poorly ventilated spaces can worsen respiratory health, particularly after exposure to fungi, mold, bacteria, and dust-related organisms in these environments, which can exacerbate asthma, rhinitis, wheezing, and eczema. Increased asthma risk has specifically been observed among individuals exposed to Aspergillus, Cladosporium, and Penicillium fungal species in these spaces. Both viable microbes and their structural components (e.g., endotoxins and cell wall fragments) can trigger inflammatory and immune responses.4
In constructed environments, infectious microorganisms spread through air, surfaces, and contact with humans. For example, poorly ventilated environments allow for aerosols to persist in the air for prolonged periods, whereas plumbing systems and wastewater channels may contain microbial biofilms that include opportunistic pathogens and, in some settings, organisms carrying antibiotic resistance genes.1,4 Transmission pathways include airborne, fomite, and waterborne routes, all of which are influenced by building design and operation.1
Outdoor vs. indoor urban microbial exposure
The outdoor urban microbiome composition varies based on soil type, the presence or absence of plants, climate, and land use, which alter its composition. Green spaces are particularly beneficial, as they promote the growth of diverse microbial communities that also enhance the air microbiome. A greater diversity in microbial composition outdoors is associated with a more resilient and health-promoting microbiome and may help limit domination by a narrower set of potentially harmful organisms.1,2
Indoors, human activities and built-in features like ventilation systems and surface characteristics modulate microbial composition, with studies identifying high levels of Streptococcus and Staphylococcus species in the indoor microbiome. Indoor environments are typically less diverse than outdoor environments and are often dominated by human-associated microorganisms.3 In spaces with poor indoor air quality, fungi such as Aspergillus and Penicillium are predominant.1
These differences in exposure can influence human health, as outdoor environments comprise more diverse microbial communities that support immune function, while indoor environments often contain occupant-derived microbes and potentially harmful microorganisms. Humans spend up to 90% of their time indoors, thus emphasizing the importance of understanding these differences and balancing microbial exposures through better ventilation, green infrastructure, and thoughtful design.1 Some studies estimate indoor time at approximately 87–90%, reinforcing the dominance of indoor exposure pathways.3,4
How Your City Has Its Own Unique MicrobiomePlay
Urban design and microbial health opportunities
Thoughtful city planning that integrates green spaces, ventilation, and balanced hygiene practices has the potential to restore beneficial interactions between individuals and microorganisms in their environment. Larger, well-designed spaces sustain functional ecosystems and diverse aerobiomes, which comprise a wider range of environmental microbes capable of reaching the surrounding air and indoor spaces. Urban rewilding, increasing plant diversity, and enhanced green infrastructure in neighborhoods are some examples of effective strategies that can enrich microbial exposure and may reduce the burden of immune-mediated diseases.2
Construction design features may also limit or promote microbial exchange, as exemplified by the inclusion of operable windows that enable a continual exchange of microorganisms between outdoor and indoor environments. Likewise, the incorporation of mechanical ventilators and high-efficiency filtration systems limits pathogen load and airborne transmission. However, increased ventilation may also introduce outdoor pollutants or allergens, highlighting trade-offs in building design.4
Built spaces should maintain optimal levels of temperature, humidity, and daylight exposure to limit the persistence of harmful microorganisms and moisture-related growth. Moisture control is particularly critical, as even small damp areas can support microbial growth and influence indoor microbiomes.4 Daylight and well-regulated indoor climates can reduce microbial persistence, while indoor plants and biophilic design elements have been proposed as possible ways to increase contact with environmental microbiota, although direct health evidence remains limited.1,2
Bioinformed design strategies balance infection control with microbial diversity by using antimicrobial or moisture-resistant materials, as well as probiotic-based cleaning systems to control pathogens. Emerging approaches emphasize “microbiome-informed” buildings, but researchers do not yet have sufficient evidence to define a “healthy” indoor microbiome or to manage it predictably to improve health outcomes.4 Together, these methods reflect a shift away from overly sterile designs toward those that support diverse microbiomes for long-term health and sustainability.1
Future directions and knowledge gaps
Urban microbiome research has transitioned from primarily studying short-term microbiome changes to a greater focus on longitudinal studies with extended follow-up periods to assess the long-term influence of microbiome composition on immunity, disease risk, and overall health. However, significant gaps remain in establishing causal relationships between microbial exposure and specific health outcomes.4
Looking forward, novel insights on design plans, airflow patterns, and building materials will accelerate translation into policy and practice. Future research should integrate smart technologies, standardized sampling methods, and interdisciplinary collaboration between microbiology, architecture, and public health.1 Through interdisciplinary collaboration, microbiome-informed approaches to urban design may eventually create healthier environments and improve population health.1
References
Joseph, T. M., Abdulmaksoud, S., Mortula, M. M., et al. (2025). Microbiomes of the built environment: A systematic literature review. Frontiers in Built Environment 11, 1657297. DOI: 10.3389/fbuil.2025.1657297. https://www.frontiersin.org/journals/built-environment/articles/10.3389/fbuil.2025.1657297/full
Matthews, K., Cavagnaro, T., Weinstein, P., & Stanhope, J. (2024). Health by design; optimising our urban environmental microbiomes for human health. Environmental Research 257. DOI: 10.1016/j.envres.2024.119226. https://www.sciencedirect.com/science/article/pii/S0013935124011319
Young, G.R., Sherry, A. & Smith, D. L. (2023). Built environment microbiomes transition from outdoor to human-associated communities after construction and commissioning. Scientific Reports 13. DOI: 10.1038/s41598-023-42427-0. https://www.nature.com/articles/s41598-023-42427-0
National Academies of Sciences, Engineering, and Medicine; National Academy of Engineering; Division on Engineering and Physical Sciences; Health and Medicine Division; Division on Earth and Life Studies; Board on Infrastructure and the Constructed Environment; Board on Environmental Studies and Toxicology; Board on Life Sciences; Committee on Microbiomes of the Built Environment: From Research to Application. Washington (DC): 2017, Microorganisms in Built Environments: Impacts on Human Health, Microbiomes of the Built Environment: A Research Agenda for Indoor Microbiology, Human Health, and Buildings. National Academies Press (US), https://www.ncbi.nlm.nih.gov/books/NBK458822/
Further Reading
Last Updated: Apr 20, 2026

